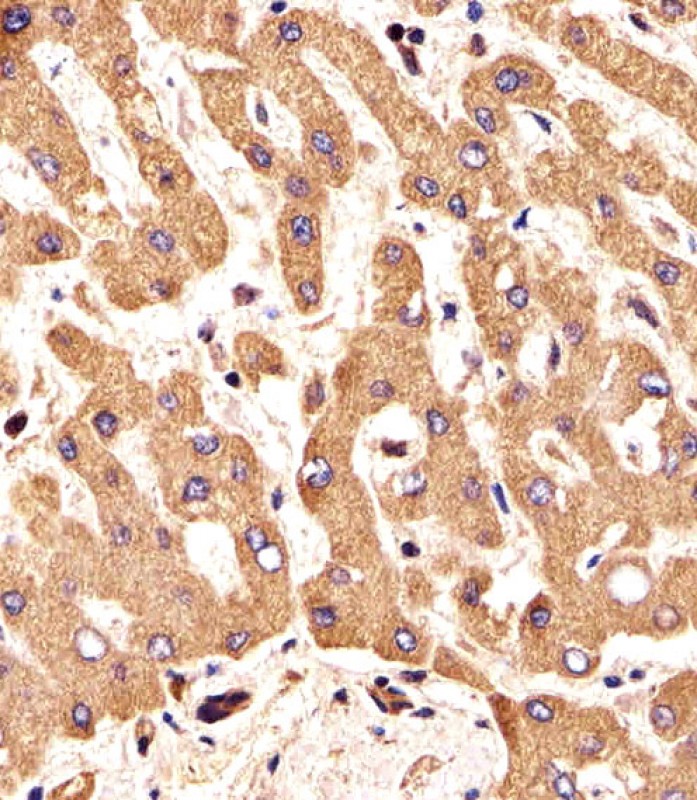

> Antigen, Antibodies, ELISA, Western Blot > Primary Antibody > Polyclonal Antibodies > FGFR2 Antibody (N-term)Brand |
Leading Biology | Catalog Number |
APC00104G |
Product Type |
Polyclonal Antibodies | Field of Research |
|
Product Overview |
We constantly strive to ensure we provide our customers with the best antibodies. As a result of this work we offer this antibody in purified format.
We are in the process of updating our datasheets. If you have any questions regarding this update, please feel free to contact our technical support team.
This product is a high quality FGFR2 antibody (N-term).
|
||
Molecular Weight |
H=92,86,77,88,92,41,28;M=92 KDa
|
||
Cellular Localization |
Antigen Cellular Localization:
Cell membrane; Single-pass type I membrane protein. Golgi apparatus. Cytoplasmic vesicle. Note=Detected on osteoblast plasma membrane lipid rafts. After ligand binding, the activated receptor is rapidly internalized and degraded Isoform 3: Cell membrane; Single-pass type I membrane protein. Note=After ligand binding, the activated receptor is rapidly internalized and degraded Isoform 19: Secreted.
|
||
Host |
Rabbit
|
||
Species Reactivity |
Human
|
||
Immunogen |
7-37 aa
|
||
Target |
This FGFR2 antibody is generated from rabbits immunized with a KLH conjugated synthetic peptide between 7-37 amino acids from the N-terminal region of human FGFR2.
|
||
Symbol |
BEK, KGFR, KSAM
|
||
GeneID |
|||
UniProt ID |
|||
Function |
Tyrosine-protein kinase that acts as cell-surface receptor for fibroblast growth factors and plays an essential role in the regulation of cell proliferation, differentiation, migration and apoptosis, and in the regulation of embryonic development. Required for normal embryonic patterning, trophoblast function, limb bud development, lung morphogenesis, osteogenesis and skin development. Plays an essential role in the regulation of osteoblast differentiation, proliferation and apoptosis, and is required for normal skeleton development. Promotes cell proliferation in keratinocytes and immature osteoblasts, but promotes apoptosis in differentiated osteoblasts. Phosphorylates PLCG1, FRS2 and PAK4. Ligand binding leads to the activation of several signaling cascades. Activation of PLCG1 leads to the production of the cellular signaling molecules diacylglycerol and inositol 1,4,5-trisphosphate. Phosphorylation of FRS2 triggers recruitment of GRB2, GAB1, PIK3R1 and SOS1, and mediates activation of RAS, MAPK1/ERK2, MAPK3/ERK1 and the MAP kinase signaling pathway, as well as of the AKT1 signaling pathway. FGFR2 signaling is down-regulated by ubiquitination, internalization and degradation. Mutations that lead to constitutive kinase activation or impair normal FGFR2 maturation, internalization and degradation lead to aberrant signaling. Over-expressed FGFR2 promotes activation of STAT1.
|
||
Summary |
FGFR2 is a member of the fibroblast growth factor receptor family, where amino acid sequence is highly conserved between members and throughout evolution. FGFR family members differ from one another in their ligand affinities and tissue distribution. A full-length representative protein consists of an extracellular region, composed of three immunoglobulin-like domains, a single hydrophobic membrane-spanning segment and a cytoplasmic tyrosine kinase domain. The extracellular portion of the protein interacts with fibroblast growth factors, setting in motion a cascade of downstream signals, ultimately influencing mitogenesis and differentiation. This particular family member is a high-affinity receptor for acidic, basic and/or keratinocyte growth factor, depending on the isoform. Mutations in the gene are associated with many craniosynostotic syndromes and bone malformations. The genomic organization of the gene encompasses 20 exons. Alternative splicing in multiple exons, including those encoding the Ig-like domains, the transmembrane region and the carboxyl terminus, results in varied isoforms which differ in structure and specificity. Isoform 1 has equal affinity for aFGF and bFGF but does not bind KGF.
|
||
Form |
Purified polyclonal antibody supplied in PBS with 0.09% (W/V) sodium azide. This antibody is purified through a protein G column, followed by dialysis against PBS. |
||
Storage & Stability |
Store at +4°C short term. For long-term storage, aliquot and store at -20°C or below. Stable for 12 months at -20°C. Avoid repeated freeze-thaw cycles.
|
||
Applications |
IF, IHC-P, WB
|
||
Dilution |
WB~~1:1000
IHC-P~~1:25
IF~~1:25
|
||
Synonyms |
Fibroblast growth factor receptor 2, FGFR-2, K-sam, KGFR, Keratinocyte growth factor receptor, CD332, FGFR2, BEK, KGFR, KSAM
|
||
Images |

All lanes : Anti-FGFR2 Antibody (R22) at 1:1000 dilution Lane 1: Hela whole cell lysates Lane 2: K562 whole cell lysates Lane 3: MCF-7 whole cell lysates Lane 4: T47D whole cell lysates Lysates/proteins at 20 μg per lane. Secondary Goat Anti-Rabbit IgG, (H+L),Peroxidase conjugated at 1/10000 dilution Predicted band size : 92 kDa Blocking/Dilution buffer: 5% NFDM/TBST.
Immunohistochemical analysis of paraffin-embedded H. liver section using FGFR2 Antibody (N-term)( APC00104G). APC00104G was diluted at 1:25 dilution. A undiluted biotinylated goat polyvalent antibody was used as the secondary, followed by DAB staining. 
Immunohistochemical analysis of paraffin-embedded H. brain section using FGFR2 Antibody (N-term)( APC00104G). APC00104G was diluted at 1:25 dilution. A undiluted biotinylated goat polyvalent antibody was used as the secondary, followed by DAB staining. |
||
Specification |
|||
Quantity |
|
||
| Select | Brand | Catalog No. | Product Name | Pack Size | Type | Field of Research | Specification | Quantity | Price(USD) | |
| 1 | Leading Biology | APR03440G | ITGA11 Antibody (N-term) | 100 μl | Polyclonal Antibodies |
|
$495.00 | Add Ask | ||
| 2 | Leading Biology | APR04537G | CMIP Antibody (C-term) | 100 μl | Polyclonal Antibodies |
|
$495.00 | Add Ask | ||
| 3 | Leading Biology | APR12422G | Human H4 Histamine Receptor (extracellular) Antibody | 50 μl | Polyclonal Antibodies |
|
$695.00 | Add Ask | ||
| 4 | Leading Biology | APR03844G | UBE2W Antibody (C-term) | 100 μl | Polyclonal Antibodies |
|
$495.00 | Add Ask | ||
| 5 | Leading Biology | APR04349G | HECTD2 Antibody (N-term) | 100 μl | Polyclonal Antibodies |
|
$495.00 | Add Ask | ||
| 6 | Leading Biology | APR03502G | IGHG1 Antibody (Center) | 100 μl | Polyclonal Antibodies |
|
$495.00 | Add Ask |
 Leading Biology Inc.
2600 Hilltop DR, Building G, B Suite C138
Richmond, CA, 94806
Tel: 1-661-524(LBI)-0262
Email: info@leadingbiology.com
Leading Biology Inc.
2600 Hilltop DR, Building G, B Suite C138
Richmond, CA, 94806
Tel: 1-661-524(LBI)-0262
Email: info@leadingbiology.com
Complete this form and click send to ask us a question, request a quote or simply say hello.

You have 0 item in your cart

You have 0 item in your inquiry list
